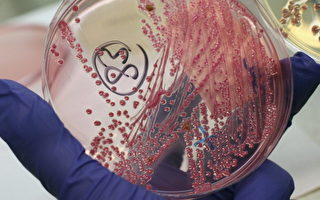
持J1签证 中国博士后在美被控走私大肠杆菌

【大纪元2025年12月27日讯】(大纪元记者林燕报导)周五(12月26日),美国联邦调查局(FBI)局长卡什‧帕特尔(Kash Patel)宣布,该机构已最终确定永久关闭J‧埃德加‧胡佛大楼(J. Edgar Hoover building)的计划。
帕特尔在社交媒体X上发帖称:“经过二十多年的努力,我们最终确定了一项计划,永久关闭联邦调查局的胡佛(大楼)总部,并将工作人员迁至(一栋)安全现代化设施。”
“我们与川普(特朗普)总统和国会直接合作,完成了其他人无法完成的任务。”他补充说。
帕特尔表示,在他接手FBI时,有一项耗资近50亿美元、直到2035年才能启动的新大楼建造计划,但他们决定放弃这一计划,转而选择将大部分联邦调查局工作人员迁至已有的里根大楼。
这一决定除了为纳税人节省下数十亿美元外,还可以立即开始过渡,而安全和基础设施升级工作已在进行中。
“一旦完成,大部分总部工作人员将迁入新址,其余人员将继续留在原地,继续为第一线增派人手。”FBI局长说。
“这项决定将资源用在了真正应该用的地方:保卫国土、打击暴力犯罪和维护国家安全。”帕特尔说 ,“以更低的成本为现有的FBI工作人员提供了更好的工具。”
“胡佛大楼将永久关闭。”他补充说。
December 26: Shutting down the Hoover Building.
After more than 20 years of failed attempts, we finalized a plan to permanently close the FBI’s Hoover headquarters and move the workforce into a safe, modern facility. Working directly with President Trump and Congress, we…
— FBI Director Kash Patel (@FBIDirectorKash) December 26, 2025
责任编辑:李寰宇#